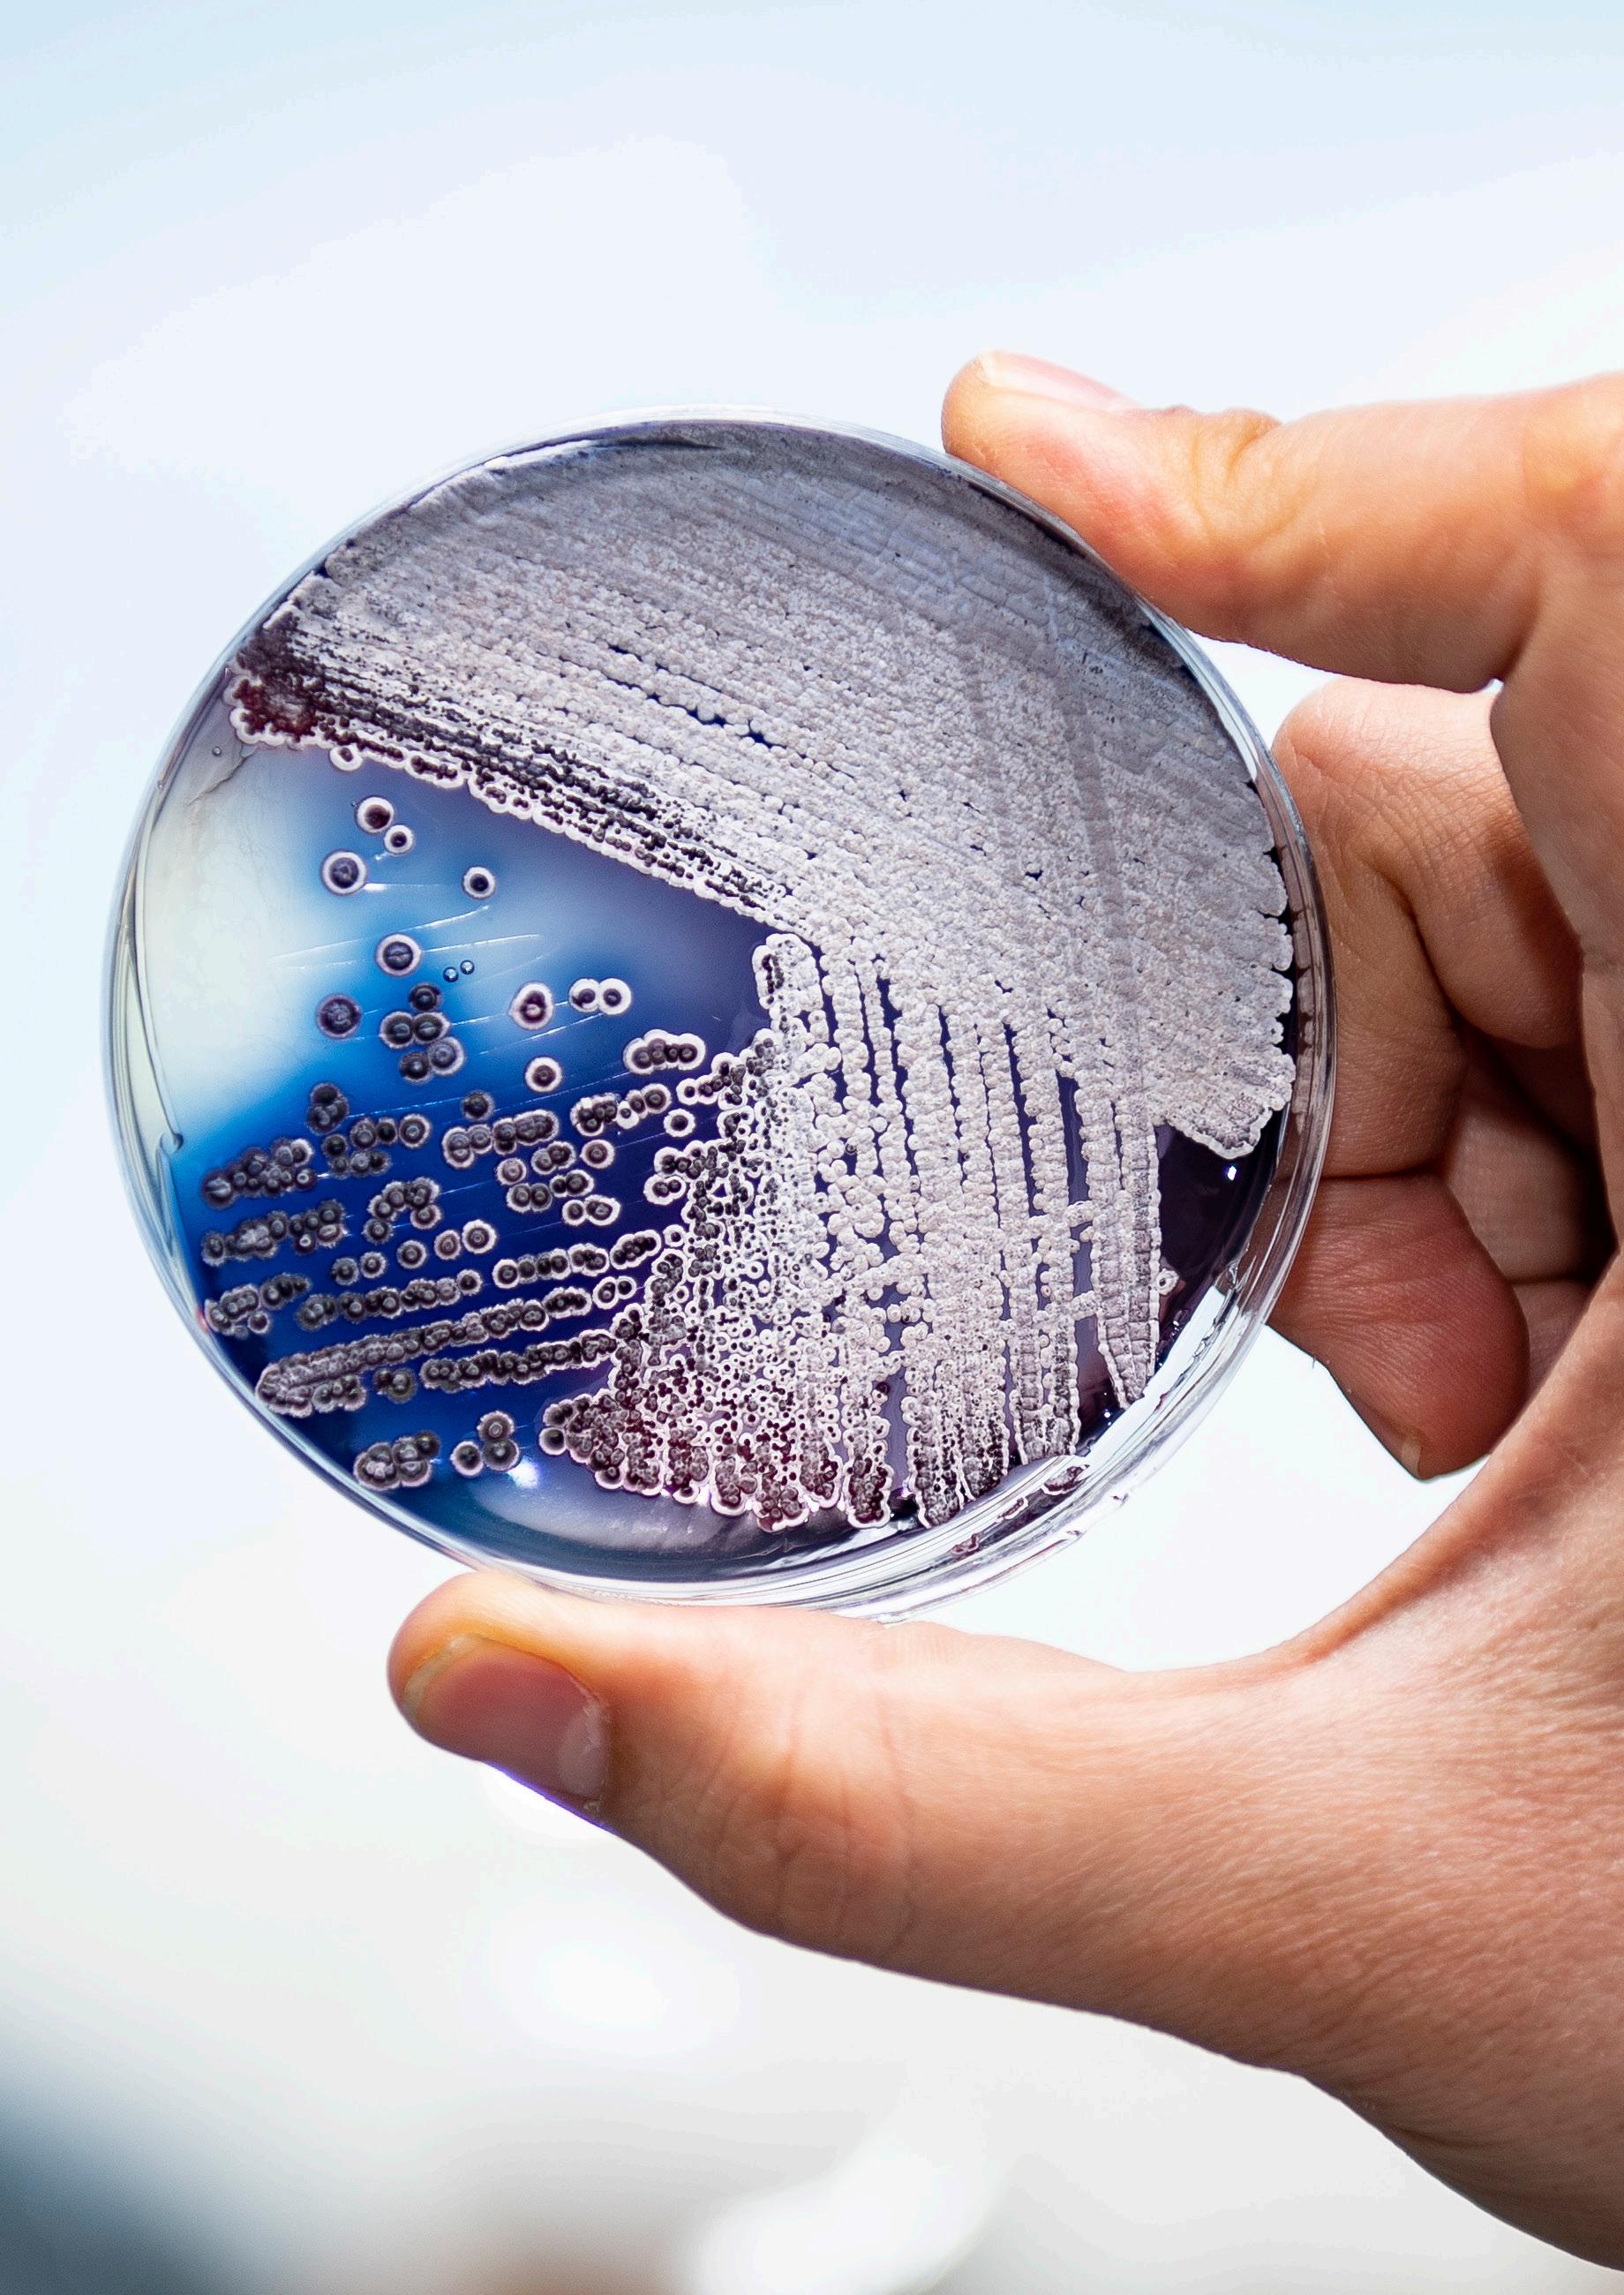

Annual Review
2023 / 2024

![]()
2023 / 2024

It is with great pride that I reflect on the remarkable progress and achievements of the John Innes Centre over the past year.
Our mission to push the frontiers of plant and microbial science has never been more critical, and this year’s work highlights our commitment to addressing pressing global challenges, whether through enhancing food security, advancing human health, or tackling the impact of climate change. These achievements reflect not only the talent and dedication of our researchers but also the collaborative spirit that drives our innovation forward.
The Next Generation Infrastructure programme, to deliver our HP3 vision, is actively underway. Following the confirmation of funding from the UKRI and the appointment of the programme team, there is plenty of progress both visible on site and behind the scenes (page 17).
In 2023, we launched the John Innes Centre’s first ever sustainability strategy which sets
out our vision for net zero and provides an action plan to aim to reach it by 2040 (page 11).
I am delighted that we secured a BBSRC Connecting Culture Award to work collaboratively with other BBSRC Institutes to better understand, value, and celebrate Neurodiversity (page 12).
We welcome Professor Anne Graham to the role of Norwich Research Park Doctoral Training Partnership, and Chair of the Graduate School. Anne will lead the Institutes into a new round of funding for our PhD programme. The appointment of a new Director of Development, Angela Bowen, to lead our fundraising campaign, will ensure delivery of our ambitious HP3 vision (page 16).
As we look to the future, the strength of our science continues to position us as a global leader in agricultural and bioscience research. Building on the great strides this year in fundamental and strategic plant and microbial science, particularly in respect to crop
It’s an incredibly exciting time for the John Innes Centre! This past year, we have made tremendous strides in shaping the future of plant and microbial science, and it fills me with optimism as we look ahead.
Our new science strategy will be addressing the most pressing global challenges, from food security to climate resilience. This strategy will drive innovation and ensure that we continue to lead the way globally in scientific excellence.
We’re also working on a bold funding strategy that will allow us to expand our impact further. By building on our strengths and forging new directions, we are paving the way for groundbreaking research initiatives that will inspire the next generation of scientists.
Our spirit of collaboration has never been stronger. Alongside our global partners, we are pushing boundaries, and it’s this shared commitment that will drive us towards a future where our research not only solves today’s problems, but anticipates tomorrow’s.
I would like to express my heartfelt thanks to Jennifer Midura Haywood and John Innes for their commitment and invaluable contributions over the years as Trustee Directors. At the same time, I am delighted to welcome Jane Langdale, James McCafferty, and Mark Searcey as Trustees, and Baroness Eliza Manningham Buller and Henry Dimbleby as Advisors to the board. We look forward to the fresh perspectives and energy they will bring to our shared vision.

improvement, we will push forward with our science strategy, launch our fundraising campaign and recruit the next generation of research leaders at the John Innes Centre.
I invite you to explore this annual review, a testament to the dedication and creativity of our team, and the far-reaching impact we strive to make in shaping a healthier, more sustainable world.
Director of the John Innes Centre

As you explore the achievements outlined in this report, it is clear that, with the dedication of our teams and the strength of our partnerships, the future is indeed bright for the John Innes Centre.
Sir Thomas Hughes-Hallett Chair of the Governing Council
The John Innes Centre (JIC) is a world-leading international centre of excellence in plant science and microbiology based at the Norwich Research Park.
For the past 110 years, JIC has been addressing global challenges through research. Our knowledge of plants and microbes combined with our creative, curiosity-driven approach answers fundamental questions and significantly impacts industrial biotechnology, society, and global development.
Healthy Plants, Healthy People, Healthy Planet (HP³), our joint strategy with The Sainsbury Laboratory, outlines our vision for delivering a
safer, healthier and more sustainable future through the power of plant and microbial science.
In collaboration with world-leading academic partners, we are uniquely positioned to lead the fundamental scientific advances needed to address three intertwined, era-defining challenges: feeding the world, global health threats, and climate change.
Home to more than 40 RESEARCH GROUPS working on a variety of plant and microbial science research projects.
In 2022, the John Innes Centre commissioned an updated socio-economic impact assessment.
For every £1 invested in the John Innes Centre, £15.29 is generated for the wider UK economy.
JIC is expected to contribute £11.2 BILLION to the global economy over the next decade.

We are committed to fostering an inclusive and supportive environment for all staff and students.
Proud to have been awarded the ATHENA SWAN GOLD AWARD in 2017, and to renew this award in 2023.

UCE G E NDER CHARTER
A founding signatory of the TECHNICIAN COMMITMENT
Our strategic programmes were rated at VERY GOOD TO EXCEPTIONAL in BBSRC’s Institute Assessment in 2022.
STAFF AND STUDENTS FROM 36 COUNTRIES
World class training for the SCIENTIFIC LEADERS OF THE FUTURE. At any one time, we are training around 100 PhD students.
15 SPIN OUTS SINCE 2002 across a range of fields, including biomedical aspects of vaccine production, development of advanced in-field diagnostic tools to speed up testing for high-profile viral infections, and support to the pharmaceutical industry and researchers with tools to screen novel anti-infective and anti-cancer compounds.
Genomic detective work has brought researchers closer to the secret of how and why grass pea produces its notorious toxin, paving the way for this ancient and climate-resilient crop to become a food of the future.
Using a newly available genome sequence of grass pea (Lathyrus sativus L.) a research collaboration led by the John Innes Centre has identified key biochemical steps that lead to the production of the neurotoxin β-L-ODAP (ODAP).
The availability of the genome sequence means the researchers can use gene editing and modern breeding methods to develop varieties of grass pea with low or zero ODAP content. This means that grass pea could be poised to make an important contribution to a more diversified and climate-resilient food system in the future.
Genomics and biochemical analyses reveal a metabolon key to ß-L-ODAP biosynthesis in Lathyrus sativus, Nature Communications. 10.1038/s41467-023-36503-2

A key molecular ingredient in vaccines, sourced from soapbark trees, has been replicated in an alternative host, opening unprecedented opportunities for the vaccine industry.
A research collaboration led by the John Innes Centre used the recently published genome sequence of the Chilean soapbark tree (Quillaja saponaria) to map the elusive chemical pathway for molecule QS-21 production and then reconstituted this in a tobacco plant, demonstrating novel ‘free-from-tree’ production of this valuable compound.
Dr Laetitia Martin said: “What is so rewarding is that this molecule is used in vaccines and by being able to make it more sustainably my project has an impact on people’s lives. It’s amazing to think that something so scientifically rewarding can bring such good to society.”
Complete Biosynthesis of the potent vaccine adjuvant QS-21, Nature Chemical Biology. DOI: 10.1038/s41589-023-01538-5

Research has brought clarity to the long-standing question of how starch granules form in the seeds of Triticeae crops – wheat, barley, and rye –unlocking diverse potential benefits for numerous industries and for human health. Starch in wheat, maize, rice and potatoes is a vital energy-giving part of our diet and a key ingredient in many industrial applications, from brewing and baking to the production of paper, glue, textiles, and construction materials. Starch granules of different crops vary greatly in size and shape. Wheat starch (and those of other Triticeae) uniquely have two distinct types of granules: large A-type granules and smaller B-type granules. The discovery of a gene involved in B-type granule formation unlocks the possibility of improving bread and pasta quality by changing starch granule size.
Initiation of B-type starch granules in wheat endosperm requires the plastidial a-glucan phosphorylase PHS1, Plant Cell. DOI: 10.1093/ plcell/koad217
Gene editing techniques have helped to identify a temperature tolerance factor that may protect wheat from the increasingly unpredictable challenges of climate change. Wheat fertility and therefore yield is highly influenced by temperature, particularly the initial stages of meiosis when chromosomes from parent cells cross over and pair to create seeds for the next generation.
Meiosis in wheat functions most efficiently at temperatures between 17-23 degrees centigrade. It is known that developing wheat does not cope well with hot temperatures and can fail during low summer temperatures. Identifying genetic factors that help stabilise wheat fertility outside optimal temperatures is critical if we are to breed climate-resilient crops of the future.
DMC1 stabilizes crossovers at high and low temperatures during wheat meiosis, Frontiers in Plant Science. DOI: 10.3389/fpls.2023.1208285

An obscure aquatic plant has helped to explain how plants avoid cracking up under the stresses and strains of growth.
The finding started with a curious observation in a dwarf mutant of the carnivorous plant Utricularia gibba. The stems of this floating plant are filled with airspaces and this means that the vascular column inside the stem can buckle when under stress. This effect would not be apparent in most plants, which have solid stems.
The researchers saw that in a dwarf mutant the central column was wavy instead of straight. They hypothesised that this wobbly spine was caused by an internal conflict, a disparity between what was happening inside the plant stem and the epidermis or skin.
“We realised that in these types of dwarf, only the epidermis, the skin of the stem, wants to be short, the internal tissue still wants to be long hence the buckling effect,” explains Professor Enrico Coen.

Brassinosteroid co-ordinates cell layer interactions in plants via cell wall and tissue mechanics, Science. DOI: 10.1126/ science.adf0752
Secrets of photosynthesis have been discovered at the atomic level, shedding important new light on this plant superpower that greened the earth more than a billion years ago.
Researchers explored how the photosynthetic proteins are made and presented a model and resources to stimulate further fundamental discoveries in this field and assist longer term goals of developing more resilient crops.
The research team used a method called cryogenic electron microscopy (cryo-EM) to image samples of chloroplast RNA polymerase purified from white mustard plants. By processing these images, they were able to build a model that contains the positions of more than 50,000 atoms in the molecular complex.
Dr Michael Webster, group leader and co-author of the paper, said: “We hope that by understanding this process better – at the detailed molecular level – we will equip researchers looking to develop plants with more robust photosynthetic activity.”
Structure of the plant plastid-encoded RNA polymerase, Cell DOI: 10.1016/j.cell.2024.01.036

On bright chilly mornings you can either snuggle down under the duvet, or leap up and seize the day. However, for photosynthesising plants, this kind of dawn spells danger, so they have evolved their own way of making cold mornings tolerable.
Research has discovered a cold “coping” mechanism that is under the control of the plant biological clock and could offer solutions to breeding more climate resilience into crops.
Cold temperatures can damage plant cells, particularly when combined with too much light or during freezing temperatures. Hence why those bright cold mornings are so dangerous to plants.
Professor Antony Dodd comments: “Crops such as winter wheat and winter oilseed rape experience cold temperatures for periods of their cultivation.” He continues: “We think that the mechanism that we have discovered could provide greater resilience of photosynthesis to cold temperatures.”
Low-temperature and circadian signals are integrated by the sigma factor SIG5, Nature Plants. DOI 10.1038/s41477-023-01377-1
The John Innes Centre will play a leading role in the UK-CGIAR Centre which aims to drive global food security by forging dynamic, new collaborations between CGIAR, UK science institutes and research centres in the Global South as well as galvanising existing partnerships.
As part of the initiative, John Innes Centre researchers will help lead a project to develop locally adapted wheat crops with enhanced resistance to wheat rusts and with elevated levels of iron, an essential micronutrient for human health.

Dr Susan Schlimpert and her team have been awarded European funding to take forward their innovative research into activating antibiotic production.
Dr Schlimpert, a group leader at the John Innes Centre, receives a European
Research Council consolidator grant, part of the EU’s Horizon Europe programme. The Schlimpert group investigates molecular mechanisms that underpin the lifecycle of Streptomyces bacteria, producers of more than 50% of all
clinically used antibiotics. “I am delighted and very excited to receive this prestigious funding which will enable us to establish a new line of research in the lab to provide a holistic understanding of the biology of Streptomyces,” she said.
Soil and root health
John Innes Centre researchers will work alongside farmers and agritech partners in a £1m research collaboration to boost crop productivity by unearthing the secrets of soil and root health.
The new project, called Thriving Roots Underpinning Total soil Health (TRUTH), is funded by Farming Futures, part of Defra and Innovate UK’s Farming Innovation Programme (FIP).
The three-year project involves setting up a research platform that allows farmers to monitor and evaluate soil/ root interactions more accurately, particularly plant control of soil microbiome and the relation between root and soil structure. This data will allow the partnership to explore the viability of an innovative sensor that can detect the biological “signature” of soil.
The John Innes Centre, biotechnology company Tropic, and British Sugar have secured funding to develop innovative gene editing approaches to protect the British sugar beet crop against potentially catastrophic losses to virus Yellows Disease.
The British Beet Research Organisation (the UK beet sugar industry’s dedicated research centre) will also support the project which aims to build resilience and productivity in this economically important crop.
Ultimately, successful project outcomes will protect British sugar beet farmers from potentially catastrophic losses to virus Yellows Disease, increase crop productivity, resilience, and sustainability, and support progression towards net zero emissions in English agriculture.


John Innes Centre researchers will work alongside farmers and agritech partners in a £1m research collaboration to boost crop productivity by unearthing the secrets of soil and root health.

A small portion of salad could soon contain your recommended daily dose of vitamin B12. Researchers from the John Innes Centre, LettUs Grow and the Quadram Institute have discovered a way to fortify pea shoots with B12 using ultrasonic aeroponic technology.
Professor Antony Dodd said: “Advances in understanding how plants interact with their environments, including new horticultural technologies such as vertical farms that use aeroponics, provides exciting opportunities to produce crops that are more nutritious,
with less environmental impact. By combining expertise in plant sciences, human nutrition and horticultural engineering, we are developing new approaches to address nutritional deficiencies at a relatively low cost.”
B12 is traditionally obtained from animal sources in our diets, and deficiency of this vitamin can lead to severe and irreversible damage, particularly to the brain and nervous system. Using this new method, a standard salad bag could contain as much B12 as two portions of beef.
The ‘Pea Protein’ project aims to have a significant impact on reducing the need for UK imports of soya. Made possible by a £1m Innovate UK grant, the collaboration involves Germinal, seed specialists and breeders, the Institute of Biological, Environmental and Rural
Sciences (IBERS) and the John Innes Centre, using a discovery made by our scientists 30 years ago.
The gene for flavourless peas was identified in the 1990s by Professor Claire Domoney’s group. While the gene did not prove to be commercially useful then, it
A genetic breakthrough has opened new opportunities for iron-fortified vegetables and cereal crops to help address the global health issue of anaemia.
John Innes Centre researchers used a newly available map of the pea-genome to identify the underlying genetic sequence responsible for two high-iron mutations in peas.
Professor Janneke Balk, a group leader at the John Innes Centre and an author of the research, said: “There are a number of opportunities arising from this research but probably the most exciting outcome is that knowledge of these mutations could inform gene editing strategies to increase iron in a wide range of crops.”
has now become now become important for the new plant protein industry. “The world has changed. People increasingly want plant-based protein in their diets rather than from animals. So flavourless peas have suddenly become flavour of the day,” said Professor Domoney.
Our Sustainability Strategy, launched in 2023, sets out actions for our journey to net zero. It is designed to embed sustainability in every aspect of the institute, and we hope to achieve net zero by 2040.
Scientific research is an energy and resource intensive endeavour. However, now more than ever, it is both environmentally and financially important to review and improve the long-term sustainability of the institute’s facilities and working practices. The strategy covers actions, objectives and targets across a range of areas including carbon footprint, energy, waste, water, procurement, biodiversity, sustainable science, research impact, travel, engagement and governance.

By 2025: IMPROVE emissions reporting and establish baselines

By 2030: Outlined below
By 2030:
SUSTAINABLE SCIENCE – Align our research into plant and microbial science to meet the challenges of a sustainable future.
ENERGY – Make efficiency improvements, such as LED lighting upgrades and improved building insulation. Progressively switch to renewable energy sources.
WASTE – Reduce waste, including single-use and disposable items where possible, and improve our recycling rates.
By 2040: EXPLORE decarbonising the heating of legacy buildings
2030: CREATE a new energy-efficient laboratory building
We recognise the urgency of the climate crisis, and are committed to embedding environmental sustainability into all of our research and innovation practices.
Professor Graham Moore FRS, Director of the John Innes Centre
At the John Innes Centre we value diversity and are committed to the creation of a positive environment which is fair, welcoming and inclusive, where everyone is treated with dignity and respect.
Diversity, including Neurodiversity, is central to the success of our research and innovation endeavours.
We are leading the UKRI-BBSRC supported project ‘Understanding, Valuing, and Celebrating Neurodiversity’, which aims to raise the profile of Neurodiverse people in research institutes, combining training, awareness building and networking activities, as well as sharing experiences of working with – and for – the Neurodiverse community.

Dyslexia: it gives me my strengths, and they have shaped my career
Director, Professor Graham Moore shared his experience of dyslexia in his blog published in January 2024.
“Having dyslexia has allowed me to think about my strengths and weaknesses objectively – and I believe this is a useful process for anyone to go through.
“My dyslexia is what makes me more strategic: I can easily visualise things, such as processes and how they should work into the future. This has been an advantage in my career and I hope that it continues to be an advantage as Director of the John Innes Centre.
“I think that dyslexia is a balance of pros and cons; it has helped me in some ways and hindered me in others. Neurodiversity is an important part of organisations, teams and society and without people that think differently we wouldn’t be as creative, efficient or strategic.”
Lab Manager, Gary Wortley has aphantasia. Inside his head there are no pictures, and things don’t appear in his “mind’s eye” as they do for many people. Gary shared his experience of aphantasia and how he remembers and interacts with information.
“When I was younger, a bandmate and I were designing a poster. I was struggling to spell a word, and my friend said, ‘visualise the word and then copy the letters onto the poster’. This made me think,” says Gary, when asked about if there was a moment that made him realise that he was experiencing things differently from others.
Rather than seeing something in his mind, Gary describes his experience as more of a “feeling of what something is, looks like or does”. There are no visual 2 or 3D pictures. He goes on to say: “It isn’t a problem, but I do get lost quite easily, and I mislay things. I often ask people to sketch things out for me, and I speak up and question from a different perspective to others when thinking about how things work. I suppose this has helped me in my career. Science is all about questions, and having people who think differently means that we solve problems and find answers creatively.”


‘JIC is a great place to work’
In our 2024 Staff Survey, 88% of respondents strongly agreed or agreed with the statement: ‘I would recommend JIC as a great place to work.’
86% strongly agree/agree
I can access the training and development that I need to do my job
82% strongly agree/agree
My manager provides me with the right level of support to perform at my best
88% strongly agree/agree
I am treated with respect by the people I work with
90% strongly agree/agree
The people I work with can be relied on when needed
I love working for JIC. Not only is the science great but also the institute manages to create a collaborative and inclusive atmosphere helping everyone to feel welcome and supported.
Research and Support Staff
Professor Yiliang Ding is the first UK plant scientist to receive a Blavatnik Award for Young Scientists. These prestigious awards recognise research that is transforming medicine, technology, and our understanding of the world, and lends a global focus to her innovative work investigating the structure and function of RNA in living cells.
“This is a great personal accolade, an honour for my group and the John Innes Centre. It’s wonderful that the global community has recognised the importance of plant science in trying to solve the critical challenges of feeding the world, improving crop yields, and combatting plant health threats,” she said.
The Ding group pioneers innovative methods of profiling the structure of RNA inside living cells. This research provides a springboard for the global use of RNA structure-guided therapeutics for human health and crop improvement.
The expertise of the Crop Transformation team received a Papin Prize, which recognises technicians who have demonstrated excellence.


The team supports science at the John Innes Centre and across the world, providing genetically modified (GM) and gene-edited plants to universities and institutes for research.
I’m honoured to receive these awards in recognition of the work of my group at the John Innes Centre and our collaborators

Professor Dame Dean FRS awarded Mendel Medal and McClintock Prize
The ground-breaking career of Professor Dame Caroline Dean FRS has addressed two central questions in biology: why do certain plants have to pass though winter before they bloom, and how do they remember that they have been exposed to cold temperatures weeks or months earlier?
Throughout her career, Caroline and her research group determined the mechanistic basis of how plants use

temperature signals to know when to flower, and discovered a cellular memory mechanism that senses and remembers long-term temperature exposure.
Her work has revealed important general concepts on epigenetic switching, the role of non-coding transcripts in transcriptional dynamics, and how non-coding single-nucleotide polymorphism can modulate silencing to underpin adaptation.
This year Caroline has been honoured with two awards: The Genetics Society’s Mendel Medal and the Barbara
Received the British Society for Plant Pathology (BSPP) RKS Wood Prize recognising excellence in the study of plant disease biology and its application in the protection of plants against pathogens.
McClintock Prize for Plant Genetics and Genome Studies.
“I’m honoured to receive these awards in recognition of the work of my group at the John Innes Centre and our collaborators, Professors Martin Howard and Yiliang Ding (John Innes Centre) and Drs Mariann Bienz and Lori Passmore (MRC, Laboratory of Molecular Biology, Cambridge). Our molecular understanding of how plants respond to seasonal signals has major implications for fragile ecosystems and agricultural practice as the extremes in our climate increase,” said Professor Dean.
Elected as a member of the prestigious European Molecular Biology Organisation (EMBO), joining a community of more than 2,000 members elected by peers in recognition of scientific excellence.

Angela joins us as Director of Development to spearhead fundraising for the Next Generation Infrastructure (NGI) programme. She joined in September 2024, bringing nearly 30 years of experience of high-level fundraising.

Dr Michael Webster has been awarded a UKRI Future Leader Fellowship, a prestigious award that will enable his group at the John Innes Centre to take their research into the molecular workings of photosynthesis and genes in an exciting new direction.
The Webster group’s research seeks to understand how plants produce photosynthetic proteins by visualising the structures and biochemical activities of the complex molecules in the chloroplast.

Anne joined the Norwich Research Park in June 2024 as the Norwich Research Park Doctoral Training Partnership (NRPDTP) Director and Chair of the Graduate School. Previously, she was Head of School of Chemistry & BioSciences at the University of Bradford and was Director of Postgraduate Research for Life Sciences for five years prior to that.


Dr Emma Banks, a molecular microbiologist and outstanding early-career researcher, has been awarded a prestigious fellowship to take forward research into the global threat posed by antibiotic-resistant bacteria.
The NGI programme team brings together the skills and people required to ensure that the development of our new, innovative and collaborative campus is a success, and supports us to deliver HP3.










The next 12 months will be an important period for us, as we prepare and plan a range of new initiatives to drive forward our strategy and ambitious plans for the future.
The John Innes Centre will develop a new scientific strategy, setting out our research priorities for the next ten years.
The new strategy will build on our joint vision with The Sainsbury Laboratory: ‘Health Plants, Healthy People, Healthy Planet’ (HP 3), which sets out how we will address critical global challenges.
Staff across the JIC will help shape the scientific strategy and future plans, identifying the major scientific challenges we’ll be tackling in the years to come. Its delivery will be led by Group Leader, Professor Cristobal Uauy.
The first step will be to complete a series of scientific reviews led by subject experts to identify key gaps and opportunities in our current research. This will shape a series of strategic recruitments over the coming year, to grow our capacity in strategic areas and support our succession planning.


The John Innes Centre will work with partners across the Norwich Research Park following the launch of the new Centre for Microbial Interactions. The virtual centre brings together the breadth of expertise within the microbiology community at the Norwich Research Park to solve global challenges in food security, human health and climate change.
The park has one of the largest concentration of microbiologists anywhere in the UK, and the new centre will capitalise on our existing collaborative culture and established infrastructure. Through the centre, we will work with our partners to create new opportunities to drive high quality research and innovation through studying microbial interactions across a wide range of disciplines and scales.
Following the confirmation of a major investment from the UKRI Infrastructure Fund in 2023, we are set to make significant progress over the coming year on our ambitious plans to deliver a world-leading plant and microbial science hub at the Norwich Research Park.
Building works on site will begin in earnest, with the redevelopment of our Horticultural Services buildings and glasshouses. In parallel, we will move through the next stages of design work for the new laboratory building and expect to apply for planning permission.
Over the coming year we will develop a series of new projects to build on our research culture: our commitment to creating a supportive and inclusive work environment. Working with our staff and students to develop our ideas, we will be running a major project focused on neurodiversity, offering a new suite of training, creating an internal network and delivering an external communications campaign. We will develop new training on micro-behaviours, improve the support we provide for our Tenure Track Group Leaders as they progress in their careers and create a new policy on Trusted Research and Innovation.

As we develop our plans for the plant and microbial science hub, we will carry out a programme of external engagement with the scientific community to scope opportunities and interest across the sector to collaborate.

We will work with partners on an application for a Doctoral Landscape Award to secure the next five years of funding for the Norwich Research Park Doctoral Training Partnership (NRPDTP). This will be a crucial part of our commitment to support postgraduate researchers and produce the next generation of plant and microbial scientists. The multidisciplinary partnership brings us together with The Sainsbury Laboratory, Earlham Institute, Quadram Institute and UEA, enabling collaboration and innovation across the Park. The partnership will be structured around the BBSRC’s central research themes of: integrated understanding of health; renewable resources and clean growth; sustainable food and agriculture; and advancing the frontiers of bioscience discovery.


